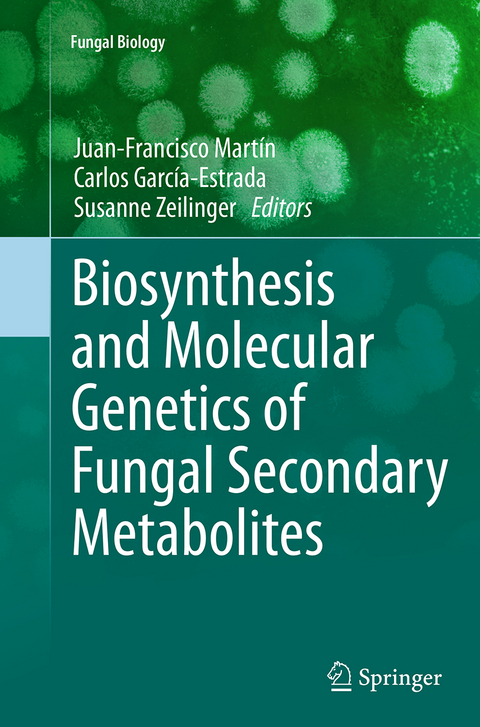
Biosynthesis and Molecular Genetics of Fungal Secondary Metabolites -

Biosynthesis and Molecular Genetics of Fungal Secondary Metabolites
Springer-Verlag New York Inc.
9781493947737 (ISBN)
Written by authorities in the field, Biosynthesis and Molecular Genetics of Fungal Secondary Metabolites provides a cutting-edge perspective on fungal secondary metabolism and underlying genetics and is a valuable resource for scientists, researchers, and educators in the field of fungal biology.
Juan-Francisco Martín, PhD University of León, Department of Molecular Biology, Area of Microbiology, León, Spain Carlos García-Estrada, DVM, PhD Institute of Biotechnology of León (INBIOTEC), Parque Científico de León, León, Spain Susanne Zeilinger, PhD Vienna University of Technology, Institute of Chemical Engineering, Vienna, Austria
Valuable Secondary Metabolites from Fungi.- Penicillins.- Cephalosporins.- Cyclosporines: Biosynthesis and Beyond.- Aflatoxin Biosynthesis: Regulation and Subcellular Localization.- Roquefortine C and Related Prenylated Indole Alkaloids.- Ochratoxin A and Related Mycotoxins.- Carotenoids.- Astaxanthin and Related Xanthophylls.- Gibberellins and the Red Pigments Bikaverin and Fusarubin.- Fusarins and Fusaric Acid in Fusaria.- Lovastatin, Compactin, and Related Anticholesterolemic Agents.- Meroterpenoids.- Ergot Alkaloids.- Fungal NRPS-dependent Siderophores: from Function to Prediction.
| Erscheinungsdatum | 14.08.2016 |
|---|---|
| Reihe/Serie | Fungal Biology |
| Zusatzinfo | 35 Illustrations, color; 30 Illustrations, black and white |
| Verlagsort | New York |
| Sprache | englisch |
| Maße | 155 x 235 mm |
| Themenwelt | Naturwissenschaften ► Biologie ► Botanik |
| Naturwissenschaften ► Biologie ► Mikrobiologie / Immunologie | |
| Naturwissenschaften ► Biologie ► Zellbiologie | |
| Schlagworte | fungal biology • Fungal Development • Metabolic regulation • molecular genetics • Secondary Metabolism |
| ISBN-13 | 9781493947737 / 9781493947737 |
| Zustand | Neuware |
| Informationen gemäß Produktsicherheitsverordnung (GPSR) | |
| Haben Sie eine Frage zum Produkt? |
aus dem Bereich


